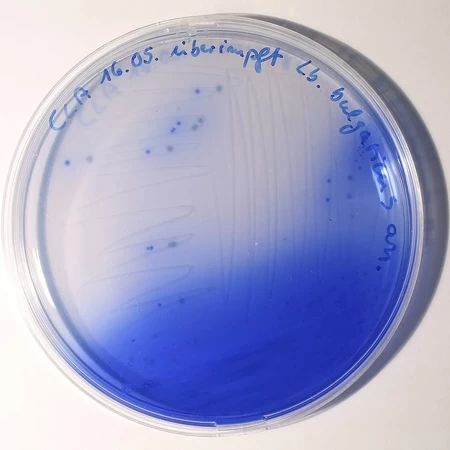

Featured Quizzes
User Quizzes
Create Quiz
Data and Charts
Word Search
Flash Cards
Badges and Games
About JetPunk
Message Board
Dark Mode

Lab Equipment by Picture #1
Write the names of the scientific, lab equipment you see.Good luck!
Rate:
Last updated: August 9, 2020
You have not attempted this quiz yet.
More quiz info >>
| First submitted | August 6, 2020 |
| Times taken | 82 |
| Average score | 60.0% | Report this quiz | Report |
2:00
Enter answer here
0
/ 10 guessed
Time Used
00:00
Best Time
00:00
The quiz is paused. You have remaining.
Copied!
Scoring
You scored / = %
This beats or equals
% of test takers
also scored 100%
The average score is
Your high score is
Your fastest time is
Keep scrolling down for answers and more stats ...

Save Your Stats
Your Next Quiz
How many countries do you know? In this quiz, you've got 15:00 to name as many as you can. Go!
Can you name the capitals cities of all 196 countries in the world?
Name the world's most widely spoken languages.
Drag the flag onto the correct country. Careful, though! One wrong move and the game ends.
1 Comments
john18015
+1
Level 57
Aug 5, 2025
Mortar & pestle should be accepted too
New and Popular
Lab Equipment by Picture




